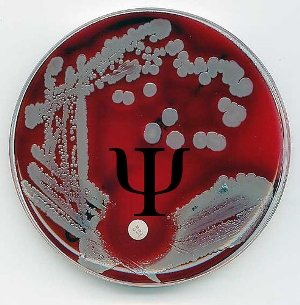

Psychology and Microbiology
by Selina

Photo Credit: Esther Simpson
I was wondering if anyone could help me by suggesting how I could club Psychology and Microbiology (have done my Master's in both) - in a major research project?
by Selina
Photo Credit: Esther Simpson
I was wondering if anyone could help me by suggesting how I could club Psychology and Microbiology (have done my Master's in both) - in a major research project?